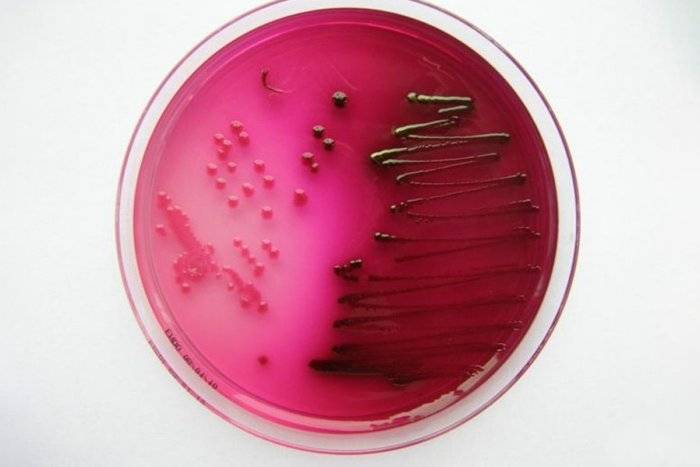

Отличия инфекционных болезней в зависимости от возбудителя
Инфекция, вызванная вирусом, отличается тем, что начало заболевания внезапное, острое, которое в среднем занимает 1-2 дня, после чего следует проявление развернутой клинической картины. К тем признакам, которыми отличается данная инфекция, относятся:
- 1-2 суток продромального срока (период между инкубационным периодом и разгаром заболевания);
- выраженные проявления интоксикационного синдрома;
- выделения слизистого либо водянистого характера;
- нет локального очага поражения.
К наиболее частым проявлениям вирусного заболевания у человека относятся: высокая температура (лихорадка), озноб, головная боль, боль в горле, кашель, общая слабость.

Бактериальная инфекция отличается тем, что заболевание развивается долго и медленно. Признаками бактериальной инфекции у человека являются:
- медленное развитие патологии;
- отсутствие выраженного интоксикационного синдрома;
- наличие локального очага поражения;
- наличие выделений гнойной природы (желто-зеленого или желтого цвета).
При гриппе у человека развивается высокая температура, которая держится около 5 дней. Если в последующем снижения нет, то это характерно для присоединения бактериальной инфекции в виде осложнения
Также важно отличать от вирусной инфекции не сопровождающиеся классическими проявлениями бактериальные. К таким инфекциям относят атипичные пневмонии
Отличие патологического процесса в зависимости от возбудителя
Отличить бактериальную инфекцию от вирусной человек способен самостоятельно, для этого потребуется понаблюдать за состоянием и определить симптомы, сроки их возникновения и другие особенности заболевания:
| Признак | Вирусная инфекция | Бактериальная инфекция |
| Распространенность | Повсеместная, часто становится причиной респираторных заболеваний | Редко возникает как первичное заболевание, обычно в качестве осложнений |
| Инкубационный период | От 1 до 5 дней | От 3 до 14 дней |
| Постоянное персистирование (нахождение) возбудителя в дыхательных путях | Характерно только для аденовирусов | Характерно для большей части возбудителей |
| Продромальный период | Достаточно выражен, длится до 24 часов | Незаметен |
| Цвет выделений из носа | Прозрачные, жидкой консистенции | Темно-зеленого, желто-зеленого цвета |
| Начало заболевания | Яркое, сопровождается высокой и быстро нарастающей лихорадкой | Стертое, температура не поднимается выше 38 градусов |
| Локальность поражения | Вначале не выражена, на первом месте общие проявления | Выражена, бактериальные инфекции проявляются отитами, гайморитами, риносинуситами, фарингитами и тд. |
| Аллергические проявления | Есть, наблюдаются почти всегда | Не характерны |
| Анализ крови | Повышено количество лимфоцитов в крови | Повышено количество нейтрофилов в крови |
| Лечение антибиотиками | Не требуется, наиболее действенным в лечении считается прием противовирусных препаратов в продромальный период | Необходимо и является самым эффективным лечением |
Отличить бактериальную инфекцию от вирусной в начале заболевания можно при тщательном анализе симптомов
Начать лечение согласно этиологии болезни важно в кротчайшие сроки
Сравнение симптоматики
Вирусы | Бактерии |
Резкое недомогание и ухудшение самочувствия. | Длительный инкубационный период с менее ярко выраженными признаками заболевания. |
Резкое повышение температуры тела, но в пределах от 37 до 38 градусов. | Постепенное нарастание температуры, которая может превышать 39.5 градуов. |
Выделение обильных жидких мокрот. | Без мокрот (в зависимости от зоны поражения) или нерегулярные густые гнойные выделения. |
Болевые ощущения во всем теле. | Боль, исключительно, в пораженном участке. |
При кишечных инфекциях, — обильная и частая дефекация жидкими массами. Рвота. |
Главные критерии, по которым отличаются вирусные инфекции от бактериальных, это конечно, анализы. Сдаются «материалы» комплексно, — кровь, мокроты, моча и т.д. Основной в этом списке – общий анализ крови.
Вирусы | Бактерии | |
Лейкоциты (WBC) | Ниже нормы или в пределах нормы | Существенно повышены |
Лимфоциты (LYM) | Выше нормы | Ниже нормы |
Нейтрофилы (NEUT) | Ниже нормы | Незначительно выше или в пределах нормы |
СОЭ | Незначительно ниже или в пределах нормы | Повышены |
Общий анализ мочи, так же, даст возможность определить наличие патогена в организме. Анализируется жидкость по цвету, запаху, плотности и другим параметрам. Основные показатели заболевания – высокий уровень белка и сахара. При этом, наличие в моче бактерий – это главное свидетельство поражения организма.
Лечение бактериальных и вирусных инфекций
Подход к терапии вирусных и бактериальных инфекций сильно различается. При обнаружении болезнетворных бактерий для лечения назначают антибактериальные препараты. Существует множество видов таких лекарственных средств, которые действуют целенаправленно на определенные виды патогенных микроорганизмов или обладают широким спектром действия. Самостоятельно назначать антибиотики и бесконтрольно их принимать недопустимо – это может осложнить процесс выздоровления и нанести вред организму. Для постановки точного диагноза и подбора лечения необходимо обращаться к врачу.
Вирусные инфекции лечат противовирусными средствами, например, такими как новая разработка российских ученых – препарат Рафамин. Это лекарство для взрослых, которое способно воздействовать на клетки иммунитета, отвечающие за распознавание возбудителя болезни. Благодаря приему препарата Рафамин сокращается длительность болезни и снижается риск развития осложнений, например, когда к вирусной инфекции присоединяется бактериальная. Это значит, что болезнь не затянется, и можно быстро вернуться к привычной жизни.
Список литературы:
- Егоров А.Ю., Проблема бактериальных осложнений при респираторных вирусных инфекциях // Текст научной статьи по специальности «Фундаментальная медицина» — 2018 г.
- Грипп, ОРВИ: проблемы профилактики и леченияhttps://cyberleninka.ru/article/n/gripp-orvi-problemy-profilaktiki-i-lecheniya
- Острые респираторные инфекции (ОРВИ) у взрослых: клинические рекомендации – 2021https://cr.minzdrav.gov.ru/schema/724_1
- М.Л. Максимов, Острые респираторные вирусные инфекции: этиология, диагностика, современный взгляд на лечение // журнал «РМЖ. Медицинское обозрение» — 2018 г.
- Минздрав РФ, Острые респираторные вирусные инфекции (ОРВИ) у взрослых // Клинические рекомендации — 2021 г.
Отличия бактерий и вирусов
Бактерии — микроорганизмы, обычно 1-клеточные, которые имеют неоформленное ядро и более простое строение по сравнению с клетками животных и растений.
Вирусы — соединения белка и нуклеиновой кислоты (ДНК или РНК), способные размножаться только в пораженной клетке.
РАЗМЕРЫ
В среднем бактерии имеют длину в несколько микрометров (1 мкм = 0.001 мм = 10−6 м ), поэтому они видны в световой микроскоп. Минимальный объект, который можно различить в световой микроcкоп, равен 1 мкм, поэтому на микробиологии на 2-м курсе студенты сидят с микроскопами, окрашивают препараты и ищут в них бактерии.
Вирусы намного меньше бактерий и имеют размеры от 0.02 мкм до 0.3 мкм. В световой микроскоп они не видны, поэтому изучаются с помощью электронного микроскопа.
Любопытно, что самые крупные вирусы (например, вирус коровьей оспы — 0.3 мкм) крупнее самых мелких бактерий (микоплазмы — 0,1–0,15 мкм; меньше быть не может, потому что нужные молекулы не поместятся в клетку). Самые крупные бактерии вполне можно увидеть невооруженным глазом. Например, бактерия Тиомаргарита (Thiomargarita namibiensis) достигает размера в 750 мкм (0.75 мм). Бактерия Тиомаргарита была впервые обнаружена на дне моря возле Намибии в 1997 году. Из физики известно, что с расстояния 20-25 см можно можно чётко увидеть точку размером 0.05 мм, но для различения объектов друг от друга их размер должен составлять около 0.2 мм.
СТРОЕНИЕ
Бактерии — это настоящие клетки, хотя и примитивные по сравнению с клетками растений и животных. Все бактерии имеют цитоплазму и клеточную облочку с поверхностными структурами (капсулы, жгутики, микроворсинки). Оформленного ядра (т. е. с ядерной мембраной) у бактерий нет, а ДНК в виде клубка просто лежит в цитоплазме. Большинства клеточных органелл тоже нет. Есть только рибосомы (для синтеза белка) и запасные гранулы. Также в клетке находится РНК.

Строение бактерии
Вирусы — это всегда внутриклеточные паразиты. Они способны размножаться только в чужой клетке, потому что сами состоят только из одного типа нуклеиновой киcлоты (ДНК или РНК, обе сразу не бывает) и белковой или белково-липидной оболочки. Вне живых клеток вирусы неактивны.

Строение ВИЧ.Обратная транскриптаза служит для синтеза ДНК по образцу РНК.
ОБМЕН ВЕЩЕСТВ
Поскольку бактерии — клетки, они имеют собственный обмен веществ и живут полноценной жизнью, растут, ходят в кино, женятся, размножаются делением пополам. Бактерии способны расщеплять углеводы и другие вещества.
Вирусы собственного обмена веществ не имеют. Они внедряются в клетку (не в любую, а только куда смогут попасть с помощью клеточных рецепторов) и заставляют ее изготавливать копии вируса. Как на настоящем заводе, идет производство копий нуклеиновой кислоты и копий вирусных белков, из которых в конце собирается новая вирусная частица. В каждой клетке образуется от нескольких десятков до нескольких тысяч копий вируса. При этом клетка чаще всего гибнет из-за прекращения продукции собственных белков, накопления токсических вирусных компонентов и повреждения клеточных лизосом. Реже клетка остается жить, а нуклеиновая кислота вируса просто встраивается в ее геном, иногда активизируясь, например, у герпетической или ВИЧ-инфекции. Иногда вирус вызывает хроническое персистирующее (англ. persist — упорствовать) течение без гибели клеток, особенно у больных с иммунодефицитами; пример — вирусы гепатита B и C.
Вирусы неплохо устроились: они поражают любые клетки — человека, животных, растений, грибов и бактерий. Вирусы, поражающие бактерии, назваются бактериофагами. На греческом «фаго» — глотаю, поэтому «бактериофаг» можно перевести как «пожиратель бактерий». А слово «саркофаг» означает «пожиратель мяса». В аптеках иногда продается «cтафилококовый бактериофаг». Теперь точно будете знать, для чего он.
Стафилококовый бактериофаг.Биологическое оружие против стафилококка
Диагностика
- Анализ крови с лейкоцитарной формулой. При бактериальной инфекции наблюдают повышенное число нейтрофилов. Когда увеличено количество палочкоядерных нейтрофилов, то говорят об остром инфекционном заболевании. Но если обнаруживаются метамиелоциты, миелоциты, то состояние больного характеризуется как опасное, и требует неотложной помощи медиков. С помощью такой диагностики можно выявить характер и стадию болезни.
- Анализ мочи. Показывает, поражена ли мочевыделительная система бактериями, а также необходим для определения степени выраженности интоксикации.
- Бактериологическое исследование с антибиотикограммой. С помощью этого анализа определяет вид возбудителя инфекции, и каким средством его можно убить (определяется так называемая чувствительность возбудителя к антибиотикам). Эти факторы важны для назначения корректной терапии.
- Серологическое исследование. Основано на выявлении антител и антигенов, взаимодействующих специфическим образом. Для таких исследований берут венозную кровь. Этот метод эффективен, когда возбудителя выделить невозможно.
- Рентген. Выполняют, чтобы дифференцировать специфические процессы в отдельных органах.
- Инструментальная диагностика. Чаще используют УЗИ или лапароскопию. Эти методы нужны для изучения внутренних органов на предмет специфических поражений.
Назначение корректного лечения, его эффективность и риск осложнений напрямую зависят от своевременности диагностики. Обращаться к врачу следует при первых же тревожных симптомах – на приеме пациенту всегда назначают анализы.
Чем отличаются бактерии от микробов
Чтобы выделить бактерии среди микробов, необходимо убедиться в том, что мы имеем дело с одноклеточным безъядерным организмом. Этим занимаются специалисты — микробиологи.
Микробиология — наука о всех типах микробов, включая бактерии, грибы, вирусы и простейшие — позволяет отличать бактерии от их микробных братьев.
В отличие от других микробов, бактерии выделяют на категории по критериям, которые относятся только к ним:
- Выживаемость в среде без кислорода;
- Форма бактерий: палочки (bacillus), круги (cocci) или спирали (spirillum);
- Есть ли у бактерий внешняя защитная мембрана, препятствующая окрашиванию внутренностей клетки;
- Как бактерии перемещаются (у многих бактерий есть жгутики, которые позволяют им передвигаться).
Большинство бактерий являются полезными, причем зачастую их используют в промышленности, пользуясь одним их ярким качеством: они могут есть то, что не может человек. Бактерии развивались, чтобы поглощать все типы продуктов, от разливов нефти и побочных продуктов ядерного распада до человеческих отходов и продуктов разложения.
Именно бактерии вызывают неприятный запах, который появляется в мусорной корзине — они перерабатывают остатки пищи и испуская собственные газообразные побочные продукты. Вы также можете обвинить бактерии в том, что они вызывают эти неловкие моменты, когда вы сами испускаете газы, или если у вас запах изо рта.
Сколько лет бактериям? Ученые до сих пор не могут ответить на этот вопрос. Предположительно именно они породили одни из самых древних окаменелостей, которым 3,5 миллиарда лет. Сколько до этого существовали сами бактерии — и представить-то сложно. Дело в том, что некоторые бактерии могут противостоять экстремальным условиям, когда либо очень жарко или холодно, либо отсутствуют питательные вещества и химикаты, которые мы обычно ассоциируем с жизнью. Они могут существовать практически вечно.
Вредные бактерии
Несмотря на наличие многие полезных свойств, некоторые бактерии могут быть патогенными, то есть вызывать заболевания и болезни. Например, именно бактерии вызвали чуму: чумная палочка Yersinia pestis убила более 100 миллионов человек. Именно бактерии ответственны за стафилококковые инфекции. Причем они отличаются способностью вырабатывать устойчивость к антибиотикам. Так что бактерии, вызывающие сибирскую язву, пневмонию, менингит, холеру, сальмонеллез, ангину и прочие болезни всегда представляют опасность для нас.
Так выглядят бактерии, которые вызывают стафилококковые инфекции
Большинство вредных бактерий удается уничтожить с помощью антибиотиков, однако если прервать лечение раньше времени, те бактерии, которые выживут, выработают устойчивость к лекарству и останутся, дожидаясь следующего шанса. Поэтому врачи рекомендуют завершать курс антибиотиков до конца.
Бактерии также можно использовать как биологическое оружие. Например, именно с их помощью в одно время искусственно устраивали эпидемии сибирской язвы. Поэтому не стоит недооценивать эти одноклеточные организмы. На самом деле мы целиком в их власти.
Бактерии вида Halomonas titanicae прямо сейчас разъедают металл, оставшийся после крушения корабля «Титаник». Представьте, на что они способны.

Бактерия Halomonas titanicae потихоньку «обедает» Титаником
Общие понятия о вирусах и бактериях
Так что такое вирус? Это латентное антитело, которое может существовать, исключительно, в живых клетках. В определенных, благоприятных для них, условиях, вирусы начинают размножаться, питаясь, теми самыми, живыми клетками, что и приводит к ярко выраженной симптоматике заболевания. Вирусы относятся к паразитирующим формам жизни – осуществляющим процесс жизнедеятельности за счет других организмов.

Инфекция поражает, практически весь, организм носителя, вызывая слабость и общее недомогание. Однако, иммунная система, в большинстве случаев, способна самостоятельно справиться с заболеванием. Способствует процессу, так же, вакцинация, подавляющая большую часть вирусов. К сожалению, прививки эффективны, только, для известных вирусов.
Разработать универсальную вакцину против еще не открытых форм, попросту невозможно. Структура каждой частицы настолько уникальна, что в мире насчитывается уже более 1000 разновидностей, из которых, около 500 поражают человека. При этом, всем известно, сколько не идентифицированных видов вирусов появилось и было изучено, только за последние годы.
Обратимся к бактериям. В отличие от вирусов, данная форма жизни относится к простейшим прокариотическим микроорганизмам. Науке известны множество различных видов бактерий. При этом, они могут мирно сосуществовать с организмом-носителем. На примере человеческого тела, можно понять, что некоторые бактерии, способны, даже, приносить пользу.
Стоит, так же, отметить, — бактерии повсеместно окружают живых существ. Они содержатся в почве, воде, воздухе, пище и т.д. Только вдумайтесь! Их суммарная масса превышает биомассу растений и животных на земле. К тому же, данные микроорганизмы играют, далеко не последнюю, а одну из важнейших ролей, в круговороте питательных веществ.
Однако, не все бактерии так миролюбивы и необходимы. Их патогенные формы, при не своевременном или не правильном лечении, могут привести к летальным последствиям, впрочем, как и вирусы. Стоит подробнее рассмотреть и сравнить симптоматику обеих инфекций и понять их влияние на организм человека.
2.
Бактерии кишечной палочки.
Бактерия состоит всего из одной клетки, которая, помимо всего прочего, не имеет ядра. У такого микроорганизма иной способ размножения и передачи ДНК. Такие существа получили название прокариоты.
Похожими на бактерии являются археи. До 1990 года их не выделяли в отдельную группу. Однако позже выяснилось, что эволюция у архей и бактерий продвигалась разными путями и генетически археи ближе к эукариотам.
Считается, большая часть бактерий безвредна, а их рост сдерживается иммунитетом человека. Некоторые из них даже приносят пользу – предотвращают появление инфекций, помогают усваивать пищу в кишечнике и т.д.
Тем не менее, часть бактерий находится по ту сторону закона. Чума, холера, сибирская язва – вот далеко не полный перечень заболеваний, которые вызывают эти маленькие убийцы.
В целом, в человеческом организме нашли приют около 39 триллионов бактерий. Их общий вес достигает двух килограммов!
Кто такой вирус?
У вируса вообще нет клеточной структуры. Это его главная отличительная черта.
В мире микробов вирусы отъявленные разбойники, которые захватывают чужие клетки и насильно заставляют их воспроизводить себе подобных существ.
Вирус в тысячу раз меньше бактерии. Поэтому он может атаковать даже других микробов.
Правда, среди вирусов тоже есть хорошие ребята – бактериофаги. Таких хищников, в ряде случаев, используют вместо антибиотиков для лечения бактериальных инфекций. Бактериофаги находят в организме микроба, вызывающего патологию и, убивают его.
Что опаснее, вирус или бактерия?
Считается, что вирус опасней. В отличие от бактерий, данный микроорганизм способен к генетическим мутациям.
Как отличить вирусную и бактериальную инфекции
Симптомы этих типов заболеваний очень похожи. «У каждого типа инфекционного заболевания есть перечень характерных симптомов, будь то острая респираторная или кишечная вирусная инфекция. Но набор симптомов чаще зависит не от природы возбудителя, а от того, какие органы поражены. Вот почему и при вирусной, и при бактериальной инфекции, затронувшей, например, желудочно-кишечный тракт будут наблюдаться общие проявления — несварение, боли, диарея, тошнота, рвота и т.д.», — говорит Валерий Савванович.
Вторгшиеся в организм вирусы и бактерии используют различные механизмы сопротивления разрушению. «Иногда они могут вырабатывать токсины, нарушающие защитную систему организма, или изменять свою форму или внешние структурные белки, чтобы замаскироваться от распознавания иммунной системой. Некоторые бактерии могут продуцировать факторы адгезии, которые позволяют им прилипать к слизистой оболочке и препятствуют их разрушению», — отмечает Владимир Сибирский.
В домашних условиях сделать однозначный вывод о том, каким типом возбудителей вызвано заболевание, почти невозможно. «Поэтому бессмысленно заниматься самодиагностикой дома – для того, чтобы выявить причину инфекции, не обойтись без лабораторной диагностики», — комментирует Валерий Савванович.
Для определения этого врачи назначают ряд анализов. Один из важнейших — общий анализ крови. «Один из маркеров бактериальной инфекции — это изменение показателей общего анализа крови, когда возникает нейтрофильный лейкоцитоз со сдвигом лейкоформулы влево. Для неосложненной вирусной инфекции таким характерным признаком будет лимфоцитоз», — говорит Валерий Савванович.
«Расшифровать» анализы может только лечащий врач. Он же назначит терапию
«Ограничиться лечением только симптомов нельзя — установить возбудителя инфекции критически важно, поскольку без устранения причины невозможно вылечить болезнь. Только правильная диагностика с помощью лабораторных исследований поможет верно поставить диагноз и назначить лечение
Иногда, если речь идет о высокозаразных инфекциях, врач может назначить соблюдение карантина», — добавляет Валерий Савванович.
Определить природу заболевания важно для корректной терапии — например, антибиотики не оказывают влияния на вирусную инфекцию, но ощутимо ударяют по иммунитету.Помните об этом и откажитесь от самолечения
Что опаснее — бактерии или вирусы?
Очевидно, вирусы могут нанести гораздо больший вред, чем бактерии. По той простой причине, что не бывает «хороших» вирусов, как в случае с бактериями (вроде бифидо- и лактобактерий, которые позволяют нам переваривать пищу). Кроме того, многие вирусы отличаются просто безобразным поведением — они могут годами существовать внутри клетки, вызывая хронические заболевания. Примером таких вирусов может быть герпес.
Из всей тройки — микробы, бактерии и вирусы, получается, что самыми опасными являются микробы, поскольку они включают в себя все микроорганизмы: как полезные, так и максимально вредные для организма. Сейчас ученые работают над тем, чтобы извлечь как можно больше пользы из «хороших» бактерий: активно исследуются возможности внедрения определенных микробов и бактерий в организм человека, которые могут дать определенные преимущества. Например, уничтожать опухоли. Кстати, именно из-за бактерий был случайно открыт пенициллин — антибиотик, который спас множество жизней.
На самом деле мы только начинаем понимать, как извлекать пользу из нашего сожительства с этими маленькими друзьями. Но после прочитанного вы еще уверены, что истинный хозяин Земли — человек?
По материалам hi-news
Общий подход к лечению бактериальных инфекций
- Устранить причину заболевания.
- Очистить организм от токсинов.
- Вылечить органы, пострадавшие от инфекции.
- Снизить выраженность симптомов и облегчить состояние.
специальной диетытуттут
Антибиотиков очень много, у каждой группы таких препаратов свой механизм действия и предназначение. Самолечение в лучшем случае не принесет эффекта, а в худшем – приведет к запущенности болезни и ряду осложнений, поэтому лечение должен назначать врач в зависимости от характера заболевания. Больной обязан лишь следовать всем предписаниям врача и не сокращать самовольно курс приёма антибиотиков и назначенную дозировку.
Следующая статья:
Антибиотики при мочеполовых инфекциях у женщин и мужчин: виды и лечение
Прокальцитонин — дополнение от 13 сентября 2017 года
Сейчас имеется возможность различать бактериальные и вирусные инфекции с помощью лабораторного анализа крови на уровень прокальцитонина, чтобы правильно принимать решение о необходимости назначения антибиотиков. Цена анализа на сентябрь 2017 в Москве — от 1.5 до 6 тысяч рублей, срок выполнения — от 1 до 5 дней.
Тест на прокальцитонин (procalcitonin test, PCT) применяется в Западной Европе с 2000 года и одобрен в США в 2005 году.
Прокальцитонин → гормон кальцитонин
Прокальцитонин образуется в С-клетках щитовидной железы. В норме ВЕСЬ прокальцитонин превращается в гормон кальцитонин, тормозящий остеолиз (медленное рассасывание костей) и уменьшающий уровень кальция в крови, но в целом физиологическая роль кальцитонина мала (его недостаток или избыток практически не влияют на костную массу). У здоровых людей в крови определяются только следовые (остаточные, минимальные) концентрации прокальцитонина: менее 0,05-0,09 нг/мл.
Прокальцитонин — показатель бактериальной инфекции
Концентрация прокальцитонина в плазме крови повышается пропорционально тяжести инфекционного процесса, достигая максимума в случае сепсиса (заражение крови). Под влиянием липополисахарида грамотрицательных бактерий и воспалительных цитокинов (интерлейкин-6, фактор некроза опухолей-альфа) прокальцитонин начинается синтезироваться также в лейкоцитах и некоторых клетках других органов (легкие, поджелудочная железа, печень).
Референтные интервалы:
- норма: менее 0.1 нг/мл. У здоровых людей.
- слабое воспаление: 0.1-0.99 нг/мл. При вирусных и грибковых инфекциях, при аллергических и аутоиммунных заболеваниях уровень прокальцитонина повышается слабо, редко достигая 1 нг/мл. Если остаются подозрения, рекомендуется повторить измерение через 6-24 часа.
- умеренное воспаление: 1-1.9 нг/мл. При локальных воспалительных очагах (ангина, гайморит, дифтерия, гастрит). Это тоже сомнительный результат, следует повторить измерение через 6-24 часа. Пороговым уровнем для разделения лихорадок бактериальной и небактериальной природы является 1.6-1.8 нг/мл. Для больных с нейтропениями (малое количество нейтрофилов) этот порог ниже: между 0,5 и 1 нг/мл.
- значительное воспаление: выше 2 нг/мл. Бывает при тяжелых бактериальных инфекциях, ожоговой болезни, сепсисе, раке щитовидной железы и некоторых формах рака легких. В указанных случаях уровень прокальцитонина возрастает от 20 до 200 нг/мл пропорционально тяжести патологического процесса.
- Уровень 10 нг/мл и выше практически всегда означает наличие тяжелого бактериального сепсиса или септического шока. Такие уровни прокальцитонина часто бывают при полиорганной недостаточности и указывают на высокий риск летального исхода. Самый высокий уровень прокальцитонина был зарегистрирован у больного с пневмонией и сепсисом (5420 нг/мл).
… и показатель эффективности лечения
Поскольку период полураспада прокальцитонина (время, за которое из крови удаляется половина вещества) составляет около 25–30 часов и практически не зависит от функции почек, его уровень позволяет следить за эффективностью лечения бактериальных инфекций. При правильной антибиотикотерапии или после успешной операции уровень прокальцитонина в крови снижается на 30–50% за сутки.
При сохраняющемся более 4 дней повышенном уровне прокальцитонина нужна коррекция лечения. Если после начала лечения не наблюдается быстрого снижения уровня прокальцитонина, прогноз заболевания сомнительный. Постоянно повышающиеся показатели свидетельствуют о плохом прогнозе заболевания.
- Галавит — уникальный, но малоизвестный российский иммуномодулятор (если вы о нем не слышали, обязательно прочитайте)
- В каких случаях принимать антибиотики при ОРВИ и ОРЗ?
- ОРВИ и ОРЗ, основные вирусы и принципы лечения
- — см. в комментариях темы.
Продолжение темы про анализ крови: отличия абсолютного и относительного лимфоцитоза.
- А вы готовы жить в мире без антибиотиков?
- Что такое «детсадовский носик»
- Ошибки в применении у детей препаратов ИРС-19, Бронхо-мунал, Рибомунил, Имудон
Отличительные особенности между вирусной и бактериальной инфекциями
Вирусы и бактерии хоть и недолюбливаются человеком, но все же необходимы для равновесия в природе. Факт, что они являются главным врагом человечества, вызывая острые заболевания, на лицо. Но помимо этого, например, без бактерий человек не смог бы существовать, так как вся пища, поступающая в желудок, после перерабатывается на полезные вещества и витамины, которые расщепляются все теми же бактериями.
Бактериальная и вирусная инфекции могут быть различены по следующим критериям:
- Вирус, проникая в организм, поражает его полностью. Отсюда общее состояние вялости, ломки и усталости. Бактерия же действует строго по определенной «акватории», отчего боль можно ощутить только в одном месте, например, ухе.
- Вирусная инфекция поражает человека в течение 1-3 дней, после чего идет на спад. Бактериальная может находиться до 15 суток, причем, не ограничивая свои атакующие действия и мощь, – в течение всех двух недель человек будет испытывать недомогания, боли, повышенную температуру и усталость.
- Вирус выводится как при помощи повышения иммунитета, так и при помощи медицинских препаратов (противовирусного действия). В этом случае он проходит быстро и надежно. Бактериальная инфекция сама по себе не проходит, поэтому если все составить на самотек, то последствия могут быть самыми драматичными. Лечение проходит только при помощи специальных антибиотиков, которые отлично справляются со своей задачей. Самолечение тут исключено.
- Вирусная инфекция сопровождается выделениями прозрачно-слизистого типа. Бактериальная подразумевает более тяжелые последствия – при борьбе иммунной системы организма человека с бактериями погибают иммунные клетки вместе с бактериальными, отчего образуются гнойные образования на месте борьбы (под кожей или на органах), что требует оперативного и профессионального вмешательства со стороны медиков.
В любом случае точный диагноз может поставить лишь специалист при помощи анализов и полного осмотра. Если по первым признакам явиться на прием к доктору, можно избежать тяжелых осложнений развития заболевания.
Бактерии и вирусы – общие сведения
Даже школьник-двоечник с грехом пополам из курса биологии знает, что:
- бактерии – это одноклеточные маленькие организмы (видимые даже под световым микроскопом) с ядерной мембраной, строение которых намного проще, чем у их сородичей (клеток животных и растений);
- вирусы – это антитела, которые способны находиться в латентной форме длительное время, но при попадании в благоприятную среду (например, организм человека) способны питаться его клетками, тем самым, размножаясь и увеличиваясь в количестве.
Бактерии будут намного больше вирусов, но и те, и другие опасны для человека. И бактерии, и вирусы вызывают различного рода заболевания.
Вирус вне организма сам размножаться не может, так как активен только при попадании в чужое тело, где есть живые клетки, а, собственно, сам корм. При попадании вируса в организм начинается «ломка» — все тело начинает выть от их «активности». Вирусы начинают поражать все клетки человека, убивая в буквальном смысле все на своем пути в течение нескольких дней. Отсюда и выходит общее вялое состояние. После такого «рейда» происходит спад активности.
Бактерии в отличие от вирусов более дружелюбно относятся к человеку, особенно это заметно по кишечнику, где микрофлора насыщена бактериями (более 200 видов), помогающих разлагать пищу. Бактерии также лояльны к человеку – поражают только определенную область тела в течение одной-двух недель. Но они сами не захотят покинуть организм, а только если их попросить (при помощи антибиотиков).
Анализ крови при бактериальной инфекции
В тех случаях, когда причиной заболевания стали различные патогенные палочки и кокки, исследование выявляет такую клиническую картину:
- повышение лейкоцитов;
- увеличение уровня нейтрофилов, но может быть и норма;
- снижение количества лимфоцитов;
- наличие метамиелоцитов, миелоцитов;
- повышение СОЭ.
Не всем может быть понятно, что такое метамиелоциты и миелоциты. Это тоже элементы крови, которые в норме не обнаруживаются при анализе, так как они содержатся в костном мозге. Но при возникновении проблем с кроветворением такие клетки могут выявляться. Их появление говорит о тяжелом воспалительном процессе.






























